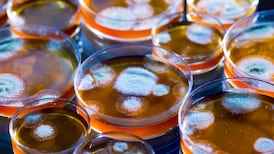
El Financiero logo

Opinión | “La discusión no es si el contenido generado por IA es válido, sino si puede presentarse como experiencia humana sin declararlo”
Opinión
La transformación del régimen político, el auge del populismo y los riesgos que enfrenta la democracia liberal ante posibles reformas constitucionales y ataques a la prensa.
Costa Rica ya decidió. Laura Fernández será la próxima presidenta, y esa certeza cambia la pregunta de fondo: ya no es si puede ganar, sino cómo va a gobernar. El país no le entregó un puesto administrativo; le entregó la jefatura del Estado y del Gobierno.